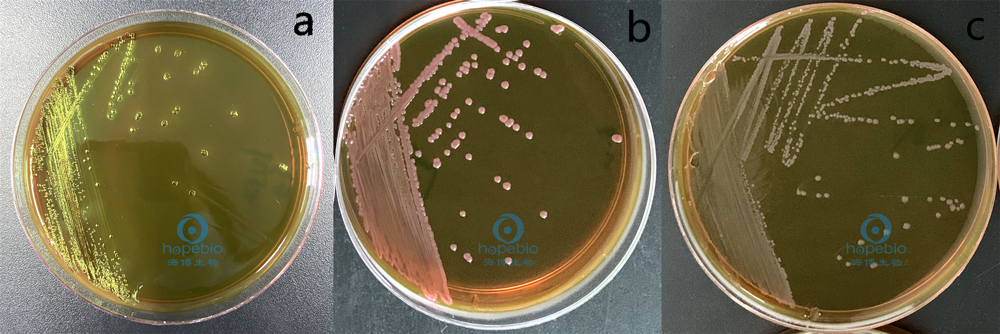
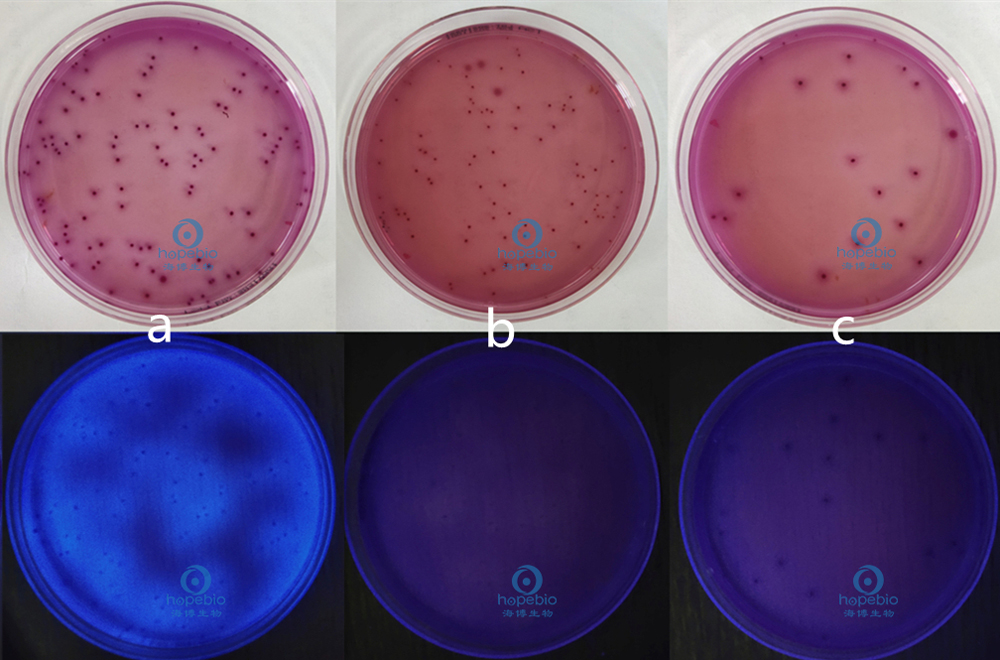

海博微信公众号
海博微信公众号
 海博天猫旗舰店
海博天猫旗舰店


 海博微信公众号
海博微信公众号
 海博天猫旗舰店
海博天猫旗舰店




一、大肠埃希氏菌简介
大肠埃希氏菌(Escherichia coli)又称大肠杆菌,广泛存在于人和温血动物的肠道中,能够在44.5℃发酵乳糖产酸产气,IMViC(靛基质、甲基红、VP试验、柠檬酸盐)生化试验结果为++--或-+--的革兰氏阴性杆菌。以此作为粪便污染指标来评价食品的卫生状况,推断食品中肠道致病菌污染的可能性。
二、参考标准
《GB 4789.38-2012 食品安全国家标准 食品微生物学检验 大肠埃希氏菌计数》。
三、检验流程
(一)MPN法

图1 大肠埃希氏菌MPN计数法检验程序
1.初发酵试验
每个样品,选择3个适宜的连续稀释度的样品匀液(液体样品可以选择原液),每个稀释度接种3管月桂基硫酸盐胰蛋白胨(LST)肉汤,每管接种1mL(如接种量超过1mL,则用双料LST肉汤),36±1℃培养24±2h,观察小倒管内是否有气泡产生,24±2h产气者进行复发酵试验,如未产气则继续培养48±2h。产气者进行复发酵试验。如所有LST肉汤管均未产气,即可报告大肠埃希氏菌MPN结果。
根据标准菌株对月桂基硫酸盐胰蛋白胨(LST)肉汤进行验证。大肠菌群、大肠杆菌和发酵乳糖的革兰氏阴性细菌产生气体,在小倒管内有气泡;其它细菌无气泡。结果如图2所示:

a:鼠伤寒沙门氏菌 b:大肠埃希氏菌 c:弗氏柠檬酸杆菌 d:阴沟肠杆菌 e:粪肠球菌 f:空白对照
图2 月桂基硫酸盐胰蛋白胨(LST)肉汤微生物质控结果
2.复发酵试验
用接种环从产气的LST肉汤管中分别取培养物1环,移种于已提前预温至45℃的EC肉汤管中,放入带盖的44.5±0.2℃水浴箱内。水浴的水面应高于肉汤培养基液面,培养24±2h,检查小倒管内是否有气泡产生,如未有产气则继续培养至48±2h。记录在24h和48h内产气的EC肉汤管数。如所有EC肉汤管均未产气,即可报告大肠埃希氏菌MPN结果;如有产气者,则进行EMB平板分离培养。
根据标准菌株对EC肉汤进行验证。粪大肠菌群和大肠杆菌产生气体,在倒立小发酵管中有气泡。结果如图3所示:

a:大肠埃希氏菌菌 b:鼠伤寒沙门氏菌 c:弗氏柠檬酸杆菌 d:阴沟肠杆菌 e:肺炎克雷伯氏菌 f:空白对照
图3 EC肉汤微生物质控结果
3.伊红美蓝(EMB)平板分离培养
轻轻振摇各产气管,用接种环取培养物分别划线接种于EMB平板,36±1℃培养18~24h。观察平板上有无具黑色中心有光泽或无光泽的典型菌落。
根据标准菌株对EMB培养基进行验证。典型大肠埃希氏菌菌落特征为具黑色中心有金属光泽,产气肠杆菌为粉红色菌落无光泽,鼠伤寒沙门氏菌为无色菌落。结果如图4所示:
a:大肠埃希氏菌 b:产气肠杆菌 c:鼠伤寒沙门氏菌
图4 EMB培养基微生物质控结果
4.革兰氏染色
挑取营养琼脂培养基上的纯培养的单个可疑菌落,进行革兰氏染色。大肠埃希氏菌为革兰氏阴性无芽胞杆菌,呈红色杆状。结果如图5所示:

图5 大肠埃希氏菌的革兰氏染色结果
5.生化鉴定
取培养物进行靛基质试验、甲基红试验、VP试验和柠檬酸盐利用试验,可选取使用大肠杆菌生化鉴定条进行生化鉴定,大肠埃希氏菌的生化反应结果为靛基质阳性、甲基红阳性、VP阴性、柠檬酸盐阴性。如图6所示:

图6 大肠埃希氏菌生化鉴定条试验结果
6.结果判定
大肠埃希氏菌为革兰氏阴性无芽胞杆菌,发酵乳糖、产酸、产气,IMViC生化试验为++--或-+--。只要有1个菌落鉴定为大肠埃希氏菌,其所代表的LST肉汤管即为大肠埃希氏菌阳性。依据LST肉汤阳性管数查MPN表,报告每g(mL)样品中大肠埃希氏菌MPN值。
(二)平板计数法

图7 大肠埃希氏菌平板计数法检验程序
1.平板计数
取2~3个适宜的连续稀释度的样品匀液,每个稀释度接种2个无菌平皿, 每皿1mL。同时取1mL稀释液加入无菌平皿做空白对照。
将10~15 mL 冷至45±0.5℃的结晶紫中性红胆盐琼脂(VRBA)倾注于每个平皿中。小心旋转平皿,将培养基与样品匀液充分混匀。待琼脂凝固后,再加3~4 mL VRBA-MUG覆盖平板表层。凝固后翻转平板,36±1℃培养18~24 h。
根据标准菌株对VRBA培养基进行验证,大肠埃希氏菌为紫红色菌落,有胆盐沉淀环;在紫外灯照射下有荧光。结果如图8所示:
a;大肠埃希氏菌 b;弗氏柠檬酸杆菌 c;阴沟肠杆菌
图8 VRBA培养基微生物质控结果
注意事项:选择菌落数在10~100CFU之间的平板,暗室中360~366nm波长紫外灯照射下,计数平板上发浅蓝色荧光的菌落。
2.结果判定
两个平板上发荧光菌落数的平均数乘以稀释倍数,报告每g(mL)样品中大肠埃希氏菌数,以CFU/g(mL)表示。若所有稀释度(包括液体样品原液)平板均无菌落生长,则以小于1乘以最低稀释倍数报告。
注:本文属海博生物原创,未经允许不得转载。
上一篇:食品中志贺氏菌的检验(下)
下一篇:叶酸测定培养基试验方法及注意事项



